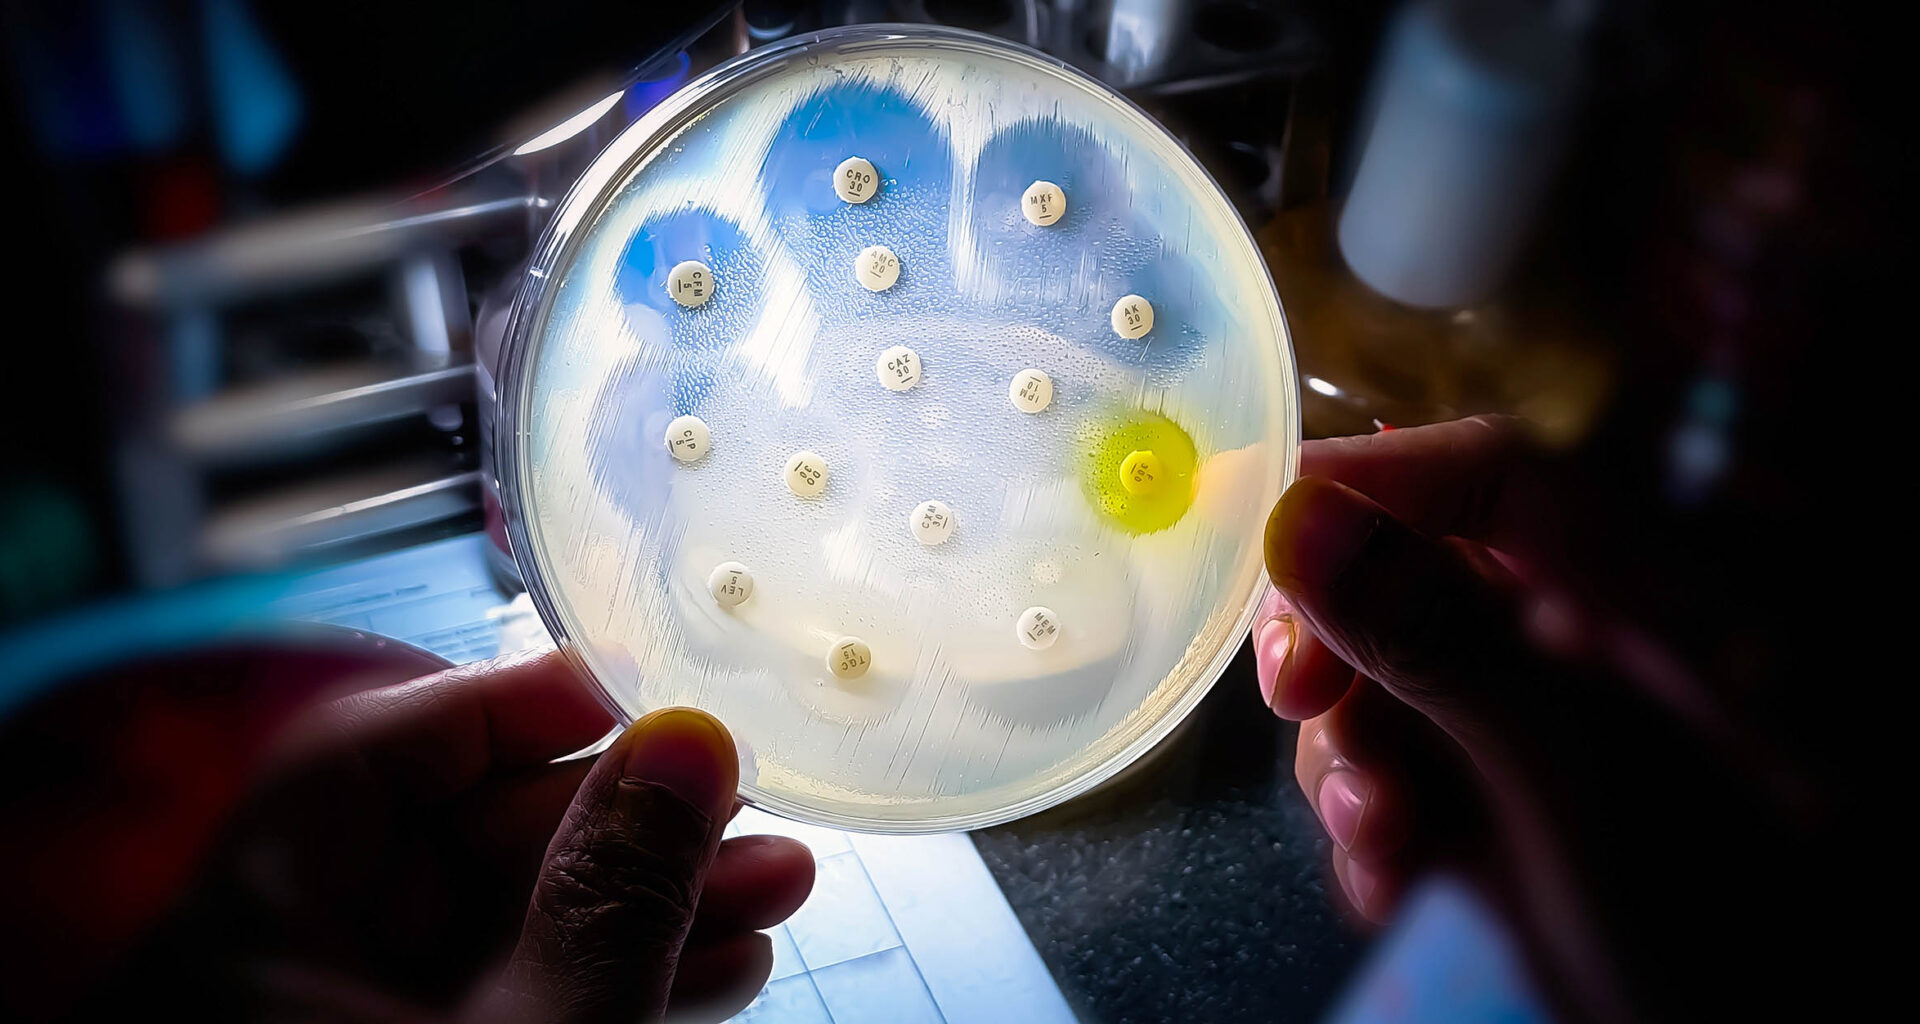
Common infections are no longer responding to antibiotics

Antibiotics changed everything. They turned fatal infections into routine fixes and made modern surgery, cancer care, and premature infant survival possible.
But the spell is breaking. Around the world, bacteria and fungi are evolving faster than our medicines. Infections linger. “Last-line” drugs fail.
A new global review led by Jilin University and Peking Union Medical College Hospital pulls together hard data from hospital labs, national surveillance, and research networks, revealing that antimicrobial resistance (AMR) isn’t a distant threat.
It’s here, it’s expanding, and it looks different depending on where you live and how your health system works. The upside? We know a lot about what slows it down, and we can do those things now.
A global problem with a local accent
Resistance doesn’t rise in a straight line everywhere. It reflects policy, practice, and everyday behavior.
In parts of Asia, E. coli and Klebsiella that make β-lactamases – enzymes that chew through our staple antibiotics – are now common.
Across Europe and the Americas, carbapenem resistance (that’s supposed to be our backstop) is creeping higher.
Some intensive-care culprits, like Acinetobacter baumannii and Pseudomonas aeruginosa, top 70% resistance in certain regions.
Meanwhile, several northern European countries keep rates in the single digits, largely thanks to tight prescribing rules, strong infection control, and robust surveillance. Same microbes, wildly different outcomes. That’s because systems matter.
It’s not just bacteria
Fungi are in this fight, too. Candida auris, a hardy hospital yeast, has developed resistance to multiple antifungal classes and can sweep through wards if you let your guard down.
Out in the environment, Aspergillus fumigatus is picking up azole resistance, in part because the same class of chemicals is used widely as agricultural fungicides.
That link between farm and hospital is a perfect snapshot of why AMR is a One Health problem: human medicine, animal health, and the environment are intertwined whether we like it or not.
Outsmarting antibiotic resistance
The review explains the tricks microbes use. β-lactamases and carbapenemases disarm drugs. Efflux pumps spit antibiotics out of cells. Small mutations reshape drug targets so our medicines can’t latch on.
And resistance genes hop between microbes on mobile DNA, traveling through wastewater, animals, and travelers.
None of that is destiny. It just means guessing and overusing broad-spectrum drugs is a losing strategy. Matching the right drug, dose, and duration to the actual bug is how you can flip the script.
Precision beats panic
Broad-spectrum “just in case” therapy got us into this mess. Precision can help get us out. That means using rapid diagnostics and, when possible, genomic testing to identify pathogens and the resistance genes they carry.
It means dosing based on pharmacokinetics and pharmacodynamics – essentially, how the drug moves through the body and how it actually disables the microbe – instead of one-size-fits-all.
It also means smart combinations: β-lactams paired with the right β-lactamase inhibitors, or carefully chosen regimens that revive older drugs like polymyxins when nothing else works. And when culture results come back, fast action is needed.
Monitoring antibiotic resistance
If you’ve ever wondered why one country’s resistance rates are low and another’s are scary, look at policy.
Stewardship programs that require cultures before carbapenems, rules that keep antibiotics off pharmacy shelves without a prescription, and investments in hand hygiene, isolation, and ventilation show up years later in resistance trends.
The review calls for exactly this kind of backbone: national surveillance that talks to hospital systems and farms, prescription controls that actually bite, and clear incentives that reward using fewer, narrower drugs when they’ll do the job.
Agriculture and the environment
Antibiotics and antifungals don’t stop at the clinic door. Prophylactic use in livestock and routine farm fungicides can select for resistant organisms that circle back to people.
Better husbandry, vaccines for animals, targeted treatments instead of blanket dosing, and phasing out agricultural chemicals that drive medical cross-resistance are tangible steps that protect both food systems and hospitals.
Wastewater monitoring and smarter sanitation help cut off another highway for resistance genes.
Drugs and better tests are needed
Conservation without innovation won’t cut it. We need new antibiotics and antifungals, especially against tough Gram-negative bacteria, plus next-generation β-lactamase inhibitors and adjuvants that block pumps or biofilms.
But equally urgent are better, faster diagnostics. Every day shaved off empirical therapy is one less day of collateral damage to the patient’s microbiome, and one less nudge toward resistance.
AI-assisted decision tools are starting to help clinicians choose smarter, sooner.
The human part of the puzzle
None of this works without people. Clinicians need time and tools to order the right tests and adjust therapy. Pharmacists and stewardship teams need the authority to step in.
Patients need straight talk: antibiotics don’t fix viruses; leftover pills aren’t souvenirs; and stopping early breeds trouble.
Public messaging should be consistent and boring in the best possible way – the kind of advice everyone can follow without a medical degree.
A slow-moving pandemic
AMR isn’t a lightning strike; it’s a tide. That’s bad news if we ignore it, but good news if we act – because tides can be predicted and resisted.
“AMR represents a slow-moving pandemic,” said Xuesong Xu, lead author of the study. “Our review shows that resistance patterns are constantly shifting, shaped by human behavior, healthcare systems, and environmental factors.”
“No country can fight this battle alone. What’s needed is a unified One Health strategy that bridges medicine, agriculture, and ecology. Only by strengthening surveillance, optimizing antibiotic use, and fostering innovation can we prevent a future where routine infections once again become deadly.”
The playbook is clear: strengthen surveillance; prescribe with precision; invest in diagnostics and new drugs; clean up agricultural use; and educate the public so antibiotics are treated like the finite, lifesaving resource they are.
Do those things, steadily and together, and we don’t just buy time. We rebuild the safety net that modern medicine rests on.
The study is published in the Medical Journal of Peking Union Medical College Hospital.
—–
Like what you read? Subscribe to our newsletter for engaging articles, exclusive content, and the latest updates.
Check us out on EarthSnap, a free app brought to you by Eric Ralls and Earth.com.
—–